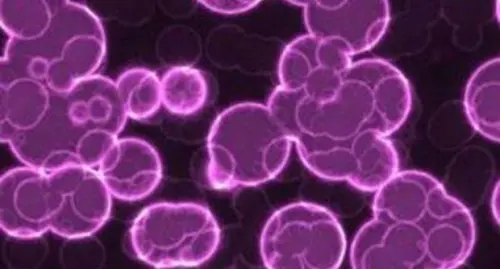
TITOLO

Tumori: Linfociti T Addestrati per Sconfiggere Cellule Maligne
di Redazione

Importante scoperta sul fronte della lotta ai tumori. Una innovativa terapia ha fornito risultati molto interessanti
Importante scoperta sul fronte della lotta ai tumori. Una innovativa terapia ha fornito risultati molto interessanti
Un team di ricercatori, durante una conferenza a Washington, ha illustrato i risultati di una nuova tecnica terapeutica basata sull'addestramento dei linfociti T, le cellule del sistema immunitario, ad individuare ed aggredire le cellule cancerose di una particolare forma di leucemia.
Dalle sperimentazioni portate avanti in numerosi centri americani sono emersi risultati a dir poco soddisfacenti. Nel 90% dei casi la leucemia è scomparsa. Percentuali di guarigione del genere, sul versante delle neoplasie, sono veramente incredibili. Anche in Italia stanno lavorando a questa strepitosa terapia anche diversi ricercatori del San Raffaele di Milano.
Chiara Bonini, numero uno della Divisione di ematologia sperimentale, presente alla conferenza americana, è felice del fatto che si è arrivati a un punto avanzato nella ricerca contro la leucemia:
"E' un approccio cui lavoriamo da tempo. Le difficoltà maggiori da superare sono state nel selezionare i sottotipi giusti di linfociti T da usare non solo nell'attacco alle cellule tumorali ma anche per mantenere una memoria duratura, e nello scegliere la molecola da usare come bersaglio sulle cellule malate".Gli studiosi americani, durante le recenti sperimentazioni, hanno cercato di bersagliare la leucemia linfoblastica acuta, patologia alquanto rara negli adulti ma che colpisce spesso i bimbi. La tecnica presenta analogie a quella usata un anno fa su una bimba inglese, Layla Richards, affetta proprio da leucemia linfoblastica acuta. In tal caso i medici notarono la scomparsa della patologia. Anche al San Raffaele, a breve, partirà una sperimentazione simile e quelle condotte negli Usa su diversi pazienti per accertare se il regresso della malattia sia, effettivamente, permanente e per scoprire se la tecnica possa essere usata anche per sconfiggere altri tumori, come quello al polmone. La Bonini, infatti, ha aggiunto:
"Per estendere ad altre forme di tumore queste metodiche dovremo probabilmente adattarle e modificarle".Speriamo bene. La scienza sta dando il massimo per combattere le neoplasie.
Articolo Precedente
Britney Spears Cerca Ragazzo Sensuale e Super Dotato
Articolo Successivo
Utero in Affitto: Lorenzin Propone Sanzione Penale



